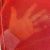

Please register now so you are approved to bid when auction starts.
It is now possible to bid at this auction.
It is no longer possible to bid at this auction.
You are now approved to bid at this auction.
You have successfully registered for this auction, pending approval to bid. Please check your email for further information.
Please contact the auctioneer for more information.

We are always adding new lots, use search to find similar items.
To be sure to win, come back before the lot closes or increase your maximum bid.
For a chance of winning, increase your maximum bid.
Another bidder has already bid this amount. For a chance of winning, increase your maximum bid.
Congratulations!
You are the winning bidder on this lot.
Unfortunately you have missed out on this lot.
Please refresh your page to see current lot status.
Please contact customer services for more help.
Your bid has been declined by the auctioneer, please contact customer services for more information.
Please check your email account for more details.
We are always adding new lots, use search to find similar items.
To be sure to win, come back before the lot closes or increase your maximum bid.
For a chance of winning, increase your maximum bid.
Another bidder has already bid this amount. For a chance of winning, increase your maximum bid.
Congratulations!
You are the winning bidder on this lot.
Unfortunately you have missed out on this lot.
Please refresh your page to see current lot status.
Please contact customer services for more help.
Your bid has been declined by the auctioneer, please contact customer services for more information.
Please check your email account for more details.
Bids do not include VAT, buyer's premium or delivery.
Clicking the confirm button is legally binding obligation to buy and pay for the lot should your bid be successful.
We are always adding new lots, use search to find similar items.
To be sure to win, come back before the lot closes or increase your maximum bid.
For a chance of winning, increase your maximum bid.
Another bidder has already bid this amount. For a chance of winning, increase your maximum bid.
Congratulations!
You are the winning bidder on this lot.
Unfortunately you have missed out on this lot.
Please refresh your page to see current lot status.
Please contact customer services for more help.
Your bid has been declined by the auctioneer, please contact customer services for more information.
Please check your email account for more details.
We have noticed that your maximum bid is higher or equal to the buy it now price for this lot.
Would you like to discard your maximum bid and proceed with the buy it now option?

|
Auction currency
|
GBP |
|
Accepted cards for registration
|
|
|
Accepted cards for payment
|
To review our FAQ's, Terms and Conditions and any information in relation to buying or selling please visit https://williamgeorge.com/terms-and-conditions-buyer
1. Definitions
1. When used in these Conditions, the following terms highlighted in bold shall have the following meanings:
Auction: a public or private sale in which Goods belonging to the Seller are sold to the highest Bidder by the Auctioneer;
Auctioneer: Auction Rebel T/A William George or any other company within the Group (including their employees and agents and any person to whom conduct of the Auction is delegated under clause 5.11);
Bid: an offer to purchase a Lot in accordance with these Conditions submitted by a Bidder:
Bidder: a person bidding for a Lot;
Buyer: a person who submits the highest Bid for a Lot that is accepted by the Auctioneer;
Buyer’s Premium: The Buyer shall pay a Buyer’s Premium of 25% plus VAT, unless otherwise indicated;
Goods: any item (or number of items) consigned to the Auctioneer by the Seller to be placed into a Lot for sale at an Auction;
Group: any entity that is a ‘subsidiary’ or ‘holding’ company as defined by s.1159 Companies Act 2006;
Lot: (a collection of) Goods listed (whether in a catalogue or otherwise) by the Auctioneer that are available to be purchased at an Auction;
Overseas Purchaser: a Buyer whose residence is outside the UK;
Seller: a person who has placed Goods with the Auctioneer for sale and who has the legal and beneficial title to the Goods listed in a Lot and/or any agent(s) authorised to act on their behalf.
VAT: Value Added Tax at [the current rate] of the Lot price, unless otherwise indicated;
1.2. Any person who attends an Auction and/or submits a Bid at an Auction held
or organised by the Auctioneer, whether by electronic means or otherwise, is deemed to have read and accepted these Conditions by reference to their attendance at the Auction or submission of a Bid.
1.3. To the extent that these Conditions are inconsistent with any special
conditions set out or referred to in the Auction catalogue or announced at the Auction, the special conditions shall prevail.
1.4. References to a ‘person’ in these Conditions shall (where the context requires) include a natural person, corporate or unincorporated body (whether or not having a separate legal personality) and that person’s successors and permitted assigns.
2. The Seller's Instructions and Warranties
2.1 The Seller warrants that: -
(a) they have the full unencumbered legal title and express authority to sell the Goods that the Auctioneer has placed into in a Lot.
(b) the description and content of the information listed by the Auctioneer (whether in a catalogue or otherwise) relating to any Goods is accurate and not deliberately or negligently misleading.
(c) Viewing is facilitated and encouraged, and the bidder should take actions to satisfy themselves through viewing and/or making the necessary additional enquiries that they are happy to place a bid with the information they have prior to bidding and not afterwards.
Requests to view and/or make additional enquiries after the buyer has placed bids and/or the auction has closed will not be permitted prior to final settlement of the invoice.
Lack of time or inability to travel to the location will not constitute reasonable grounds for defaulting on payment. If an enquiry is submitted and no answer is provided prior to the close of auction, then the auctioneer accepts no liability for any bids placed and the general rule of thumb for bidders should be followed at all times namely If you are unsure, do not bid.
(d) subject to any contrary powers of the Auctioneer set out in these conditions, he will sell the Goods placed in a Lot for the price indicated in a Bid submitted by a Buyer providing that the conditions in clause 4.1 are satisfied; and
(e) he will not contact any Buyers or potential buyers directly in relation to a sale of any Goods whilst they are listed in a Lot.
2.2 If the Seller’s instructions are given by the Seller’s agent, the Seller’s agent warrants that he has the Seller’s authority: -
(a) to instruct the Auctioneer;
(b) to give the warranties set out in clause 2.1 above; and
(c) to instruct the Auctioneer to act in accordance with any special conditions.
3. The Auctioneer's Remuneration
3.1. The Auctioneer’s remuneration shall be such as has been agreed between the Seller and the Auctioneer.
3.2 The Auctioneer may (in his discretion) deduct his remuneration from monies received from the Buyer before accounting to the Seller for the balance.
4. General rules governing bidding and buying
4.1 If a Bidder submits a Bid to purchase any Lot(s), they must complete the transaction with the Seller providing:
(a) their Bid has been accepted as the highest value Bid for the Lot by the Seller; once the Auction for that Lot has closed;
(b) the Auctioneer declares that Bidder to be the Buyer in accordance with clause 5.7 and
(c) the value of their Bid is at least equal to or greater than any minimum reserve price for the Lot set by the Seller (if any).
4.2 Upon satisfaction of the conditions in clause 4.1 a Buyer can only terminate a contract to purchase the Lot if the Goods comprising the Lot do not materially comply with the information provided in the Auction catalogue in relation to them and any such issue should be raised with the vendor and auctioneer at the earliest possible opportunity and in any case within 10 days of receipt of the goods.
4.3 Unless the Auctioneer has previously acknowledged in writing that the Bidder bids as agent on behalf of a named principal, every Bidder shall be taken to bid on his own behalf as principal.
4.4 Placing a Bid entitles the Auctioneer and any Seller to rely on the Bid as a genuine offer to purchase the Goods contained in the Lot.
4.5 If the Auctioneer has earlier acknowledged in writing that the Bidder bids as agent on behalf of a named principal, the Bidder warrants that he has the authority of his principal to make each Bid he makes.
4.6 The Bidder has the right to view all Lots. If the Bidder wishes to view a Lot, the Bidder must contact the Auctioneer at enquiries@wgandco.com The Bidder must give the Auctioneer a minimum of 24 hours’ notice to arrange a viewing of a Lot. Please note that the Auctioneer cannot guarantee any viewing of any Lot in the final 24 hours of the Auction. A refundable deposit may be requested at the Auctioneers discretion to facilitate viewing of lots.
4.7 Any request for information on a lot, must come via email, either through the lot enquiry form on each lot, or via email to - enquiries@wgandco.com Potential bidders must register for an auction to receive information about a lot.
5. Conduction of the Auction
5.1 The Auctioneer offers each Lot as an agent of the Seller and not as principal unless otherwise indicated in the Auction catalogue.
5.2 Any Lot may be subject to a minimum reserve price set by the Seller unless otherwise indicated in the Auction catalogue.
5.3 The Seller or his representative or the Auctioneer on his behalf may Bid for any Lot unless otherwise indicated in the Auction catalogue.
5.4 The Auctioneer may at any time before the fall of the hammer withdraw or divide any Lot or combine any Lots.
5.5 With the previous written consent of the Seller, the Auctioneer may sell any Lot by private sale before or after the Auction.
5.6 Any person wishing to place a Bid for a Lot at an Auction organised by the Auctioneer must register with bidspotter.co.uk, i-bidder.com, the- saleroom.com wgandco.com or any other website we advertise on, their relevant details and register a valid credit or debit card before they will be able to Bid.
5.7 A Bidder who submits the highest value Bid for any Lot before an Auction is closed may be declared as the Buyer by the Auctioneer.
5.8 If a Bidder submits a Bid within 10 minutes or less of the closure of any Auction, the Auctioneer reserves the right to automatically extend the time during which Bids can be submitted for a Lot by ten (10) minutes.
5.9 The Auctioneer may decide whether there is a dispute between Bidders, summarily determine the dispute or immediately again offer the Lot for sale, in each case without being required to give a reason.
5.10 The Auctioneer shall in every other respect decide how the Auction is to be conducted and without being required to give a reason.
5.11 The Auctioneer may in his sole discretion delegate to a person whom he believes to be competent to conduct the auction in accordance with these Conditions.
5.12 The Auctioneer reserves the right to reject any bids which the Auctioneer feels in its sole discretion does not reflect reasonable value.
5.13 The Auctioneer has a right to report suspicious activities to the relevant authorities, at any time.
5.14 The Auctioneer shall notify all successful Buyers via email by way of invoice or payment request. Buyers can also confirm which lots they have won within their account on the website www.williamgeorge.com
5.15 The Buyer can access the Auction at
www.wgandco.com
www.bidspotter.co.uk
www.i-bidder.com
www.the-saleroom.com
5.16 We cannot be held liable for any errors on the website, problems with registration / accepting bids.
5.17 The description of the item should hold precedence over the photographs. We reserve the right to use stock / catalogue images if original photographs cannot be used. Caution should be used when bidding on an item with only a stock image, as colours and sizes of an item can vary from the sale item. No warranty is given.
6. After the Sale
6.1 Upon the Auctioneer declaring the Auction for any Lot to be closed and the Lot to be sold, the Buyer shall immediately arrange to pay the value detailed in clause 6.5 to the Auctioneer by way of direct payment into the nominated bank account of the Auctioneer (details of which shall be provided to the Buyer by the Auctioneer).
6.2 Payments shall be in pounds sterling (£) (unless otherwise indicated).
6.3 All prices are exclusive of VAT or other applicable taxes, delivery charges and insurance unless otherwise indicated by the Auctioneer (whether in the catalogue or otherwise).
6.4 Within [1] business day of the closure of the Auction in relation to any Lot the Buyer shall confirm the identity of any person on whose behalf he has purchased the Lot (if any).
6.5 The Buyer shall pay the following sums to the Auctioneer in full within 2 days of the Auction:
(a) the balance of the price due for the Lot together with any VAT due (including but not limited to the Buyer’s Premium); or
(b) where the final price for the Lot was not immediately determined upon the closure of the Auction for the Lot, the value as summarily determined by the Auctioneer, whose determination shall be final and binding, of all or part of any Lot.
(c) where the total amount payable is less than £1000 then the buyer has the option of making payment by Credit or Debit Card by following the links in the invoice emailed to them. It is the responsibility of the buyer to undertake this action and payments will not be automatically debited from any registered card following the close of auction.
(d) where the total amount payable is equal to or in excess of £1000 then payment by card will not be facilitated and a bank transfer will be required. A bank transfer can still be made for payments under £1000 and for payments of this amount the buyer may select their preferred method of payment. No other payment methods are accepted.
In every case time shall be of the essence. Deadline is 16:00hrs on the second day after the auction.
6.6 The Auctioneer may at any time in his sole discretion grant the Buyer an extension of time, in which case the Buyer shall pay the auctioneer in full in accordance with such extension before moving or removing the Lot.
6.7 If the Buyer fails to make any payment due to the Auctioneer under these Conditions by the due date for payment, then, without limiting the Auctioneer’s remedies under these Conditions, the Buyer shall:
6.7.1 be contacted by the Auctioneer by email and telephone;
6.7.2 pay storage charges for the Lot at £20 per lot per day (more substantial items such as cars, plant, machinery or with a value over £10,000 shall be charged at £50 per Lot per day);
6.7.3 be responsible for paying any transportation costs of the Lot, this includes any charges connected with returning the item back to the Seller;
6.7.4 pay interest on the overdue amount at the rate of 8% per annum above the Bank of England’s base rate from time to time. Such interest shall accrue on a daily basis from the due date until actual payment of the overdue amount, whether before or after judgment. The Buyer shall pay the interest together with the overdue amount.
6.8 Until the Buyer has complied with clause 6.5 above: -
(a) title to any Lot shall not pass to the Buyer;
(b) the Lot shall be at the Buyer’s risk;
(c) the Auctioneer shall have a lien over any Lot purchased by the Buyer at the Auction; and
(d) if the Buyer effects or purports to affect a resale or any other disposition of all or part of the Lot, the Buyer shall hold the proceeds of resale or other disposition on trust for the Auctioneer and the Seller.
6.9 On written request by the Highest Bidder the Auctioneer shall provide a VAT invoice in a proper form, if appropriate.
7. Removal of the Lot
7.1 The Buyer may not remove their Lot until after the end of the Auction and the Auctioneer has confirmed that they are holding cleared funds received from the Buyer without the prior written consent of the Auctioneer.
7.2 After paying the sums specified in clause 6.5 above, the Buyer must remove the Lot bought within 5 days of the end of the auction. In each case time shall be of the essence.
7.3 The Auctioneer may at any time at his sole discretion and on terms reasonably specified by him grant the Buyer an extension to the time specified in clause 7.2 above.
7.4 If the Lot bought is or includes a motor vehicle, no warranty is given by the Auctioneer that the vehicle may safely or lawfully be driven on any road.
7.5 When removing any Lot, the Buyer: -
(a) is responsible for detaching any Lot fixed to land and must do so safely and lawfully and must not use flame cutters, explosives or any other dangerous equipment or process without previous written permission signed by or on behalf of the Auctioneer; a written Health and Safety plan with method statement may be required.
(b) must use safe and lawful means of removing the Lot;
(c) shall indemnify the Auctioneer and Seller against any loss damage legal or other expenses and any claim arising from the detaching of the Lot or its removal; and
(d) shall have adequate insurance in respect of such indemnity and shall on request produce to the Auctioneer a receipt for the last premium due or other sufficient evidence that such insurance has been affected and remains in force.
7.6 The Auctioneer reserves the right to stop the removal of any Lot if in their sole discretion they do not believe the Lot is being moved in accordance with clause 7.5 above.
7.6.1 It is the Buyers sole responsibility to arrange for collection or delivery of the Lot.
7.7 Lots will not be released, even when purchased, if there is an outstanding invoice, in this or another auction.
7.8 Purchasers should contact the vendor or agent, once an invoice has been paid to ensure there are no lifting out fees for large, outsized or dangerous goods.
7.9 There is no guarantee of collection in the first 48 hours after an auction.
7.10 Once an item is removed from the seller’s location by the buyer or a third party on their behalf, then it is deemed to be acceptable and correct. If in doubt, then the buyer is advised not to remove the item and inform the vendor and auctioneer immediately to seek a resolution of the case at the earliest convenience.
7.11 Any issues relating to an item should be taken up with the vendor at the point of collection.
8. Liability of the Auctioneer
8.1 Goods sold in any Lot are sold as seen, with all faults and imperfections and the Auctioneer is not responsible for any defects whatsoever (whether latent or not).
8.2 No warranty or representation of any kind is given or authorised to be given by the Auctioneer with regards to any Lot.
8.3 The Auctioneer has no liability to the Buyer for any delivery or collection costs. If the Buyer is unable to collect any Lot, the Buyer is to contact the Seller, once the invoice has been paid.
8.4 The auctioneer is acting as the sales agent for the lots in auction. Any problems with a lot should be taken up with the vendor.
9. Overseas Purchasers
9.1 If the Buyer is an Overseas Purchaser they must advise of their intentions to export the Lot immediately and notify the sales co-ordinator of the Auctioneer by email: accounts@wgandco.com
9.2 Overseas Purchasers will be required to provide the following information: (a scanned copy of):
(a) their passport(s);
(b) another form of identity, (i.e. drivers licence, name, address, UK agent
(if any), telephone and fax numbers);
(c) full details of their national bank and their UK corresponding bank; and
(d) details from their bank confirming method of payment.
9.3 It is the Buyers’ responsibility to ensure that:
(a) the country to which the Goods are destined to got to have no import restrictions on the Goods that they have purchased;
(b) the country has no import licence restrictions or a restriction on currency allocation;
(c) the country has no prolonged inspection procedure, which might cause excessive delay in allowing the Goods to be imported;
(d) they employ a reputable freight-forwarding organisation; and
(e) the Buyer has read and agreed with these Conditions.
9.4 If there are any special arrangements that the Buyer wishes to make with the Auctioneer, the Buyer must contact the Auctioneer at least three business days before an Auction takes place.
9.5 We reserve the right to insist a deposit is paid before bidding from an overseas bidder.
10. VAT and subsequent Refunds
10.1 All Buyers intending to export a Lot will be charged an additional deposit equal to that of the VAT due on each Lot purchased.
10.2 In order to qualify for a refund, the Goods must be exported in accordance with relevant export regulations and valid written evidence of such compliance shall be sent by the Buyer to the vendor at their registered address and to the Auctioneer within 28 days of the date of collection to the following address on official company headed notepaper signed by the Buyer: William George, Allia Future Business Centre, Peterborough, PE2 8AN. At no time does the auctioneer take ownership of any goods sold in auction and therefore accepts no liability for VAT refunds unless specifically agreed with all parties prior to the sale. The auctioneer seeks only to facilitate communication between buyer and seller in order to ensure all parties are treated fairly during the transaction.
10.3 Where satisfactory evidence is not provided, goods will be subject to UK VAT at the standard rate of export and the Buyer will forfeit any deposit they may have paid in accordance with this clause 10.
10.4 The Auctioneer is unable to refund the VAT on the Buyers’ Premium in any circumstances.
10.5 If the Buyer chooses to export their purchases using their own transport, then VAT will be levied and refunded upon satisfactory documentation supporting the removal of the Goods purchased assuming the terms of clause 10.2 are satisfied.
10.6 Notwithstanding any other clause in these Conditions the Auctioneer reserves the right to refuse:
(a) to accept any Bid from a Bidder; or
(b) to sell any Lot (in whole or in part) to a Buyer.
11. Default by the Buyer
11.1 If at any time the Buyer fails to pay any of the sums under these Conditions when they fall due or to remove any Lot by the time specified in clause 7 above (or any extension granted under clause 7 above) the Auctioneer may rescind the sale of that Lot, in which case any deposit shall be forfeited, and that Lot may be resold by Auction or privately by the Auctioneer.
11.2 If the Auctioneer has rescinded the sale but the Buyer has removed the Lot bought, the Auctioneer shall be entitled upon serving reasonable advanced written notice on the Buyer, to enter upon any premises where he believes the Lot to be and safely remove it.
11.3 If the Auctioneer has rescinded the sale and the Lot has been resold, the Buyer shall make good any deficiency, namely: -
(a) the sale price less the resale price; and/or
(b) the costs of and costs incidental to the resale of the Lot.
11.4 If the Buyer has failed to remove any Lot by the time specified in clause 7 above (or any extension granted under clause 7 above) and as a result the Seller is unable to give vacant possession on disposing of or relinquishing any interest in the premises from which the Lot should have been removed, the Buyer shall compensate the Seller for any loss arising from their failure to give vacant possession.
11.5 If at any time the Buyer in any way breaches or defaults under any of these Conditions, the Auctioneer reserves the right (without prejudice to any other rights) to issue proceedings 28 days after the Buyer’s initial default or breach of these terms. The Auctioneer’s claim shall include, but not limited to, any loss of earnings (buyers commission), any administration charges, any storage charges and any legal fees associated with the Buyer’s breach or default (all amounts will exclude VAT).
11.6 The Auctioneer reserves the right to recover any outstanding charges from the Buyers payment card used to register for the Auction.
11.6.1 if the card used to register is fraudulent, registered to a third party or does not have enough funds on it to cover the cost, a £25 plus Vat fee will be added to the invoice.
11.6.2 if we have to take payment from a registered card, we will endeavour to take from the invoice, in descending order, the whole amount, half the amount, one quarter of the amount, our premium plus Vat, £100 and then £50.
11.6.3 if the attempt to take payment is unsuccessful then we will charge £5.00 per transaction to recover the funds in 11.6.2
11.6.5 Bidders who submit charge backs after non-payment of an invoice will be charged the following
(a) Administrative charge of £250 plus VAT to defend the charge back.
(b) Storage charges will start immediately the Charge Back notification is received from our bank for a minimum of 28 days at a rate of £50 per item per day, plus Vat. We will also look to recover all of our premium.
(c) All Chargebacks will be pursued through the courts.
11.6.6 Invoices that are outstanding 10 days after the end of the Auction will have the funds debited direct from registered bank card. This will include but not limited to the Buyer’s Premium, storage and transport costs and Vat.
11.7 If the Auctioneer issues proceedings the following costs shall be payable by the Buyer:
11.7.1 The solicitor costs varying from £150 - £250 plus VAT for the issuing of proceedings;
11.7.2 £10 plus VAT for the initial letter sent by the solicitor; and
11.7.3 any court fees that are incurred, including but not limited to £90 lost wages, travel costs and £165 hearing fee.
11.7.4 Our solicitors rate for attending court is £300 plus VAT per hour, plus expenses.
11.7.5 Our staff rate for processing a legal claim is £70 plus VAT per hour plus expenses.
11.8 Any Buyer who is in default or breach under these terms shall be banned from any Auction held by the Auctioneer, Bidspotter, ibidder, the-saleroom and any other platform we advertise on.
11.9 Items that storage charges are levied on can be collected with 48 hours notice. No charge will be levied during the 48-hour notice period.
11.10 After the storage period of 28 days has ended the vendor may request the items to be returned. The cost of this transport will fall on the defaulter.
11.11 The security and integrity of the bidders account is their responsibility. Bidders are expected to take reasonable actions to preserve the integrity of their account and this is assisted by the requirement of passwords etc to log in. Appropriate care should be taken to ensure other members of the household or those with access to shared computers cannot gain access to bidding accounts without permission from the account holder and where this has not been done the bidder shall be liable for any bids placed on their account by persons without prior consent to do so.
Other factors shall be considered in determining the legitimacy of any claims such as other recent bidding activity, the amounts entered, time of bids placed etc.
12. Data Protection
12.1 The Buyer acknowledges and agrees that (as provided in the Auctioneer’s Privacy Policy) The Auctioneer may collect, process and store personal data and feedback regarding the Buyer’s transactions with The Auctioneer and share this personal data with any Sellers who are entering a contract with the Buyer. This is on an ongoing basis to ensure the integrity and reputation of The Auctioneer and to allow The Auctioneer, Sellers and Buyers to complete the transaction.
For further information on the data collected, processed and stored by The Auctioneer on Seller’s and Buyer’s, please refer to The Auctioneer’s Privacy Policy.
13. Waiver
13.1 No failure or delay by the Auctioneer to exercise any right or remedy provided under this agreement or by law shall constitute a waiver of that or any other right or remedy, nor shall it prevent or restrict the further exercise of that or any other right or remedy. No single or partial exercise of such right or remedy by the Auctioneer shall prevent or restrict the further exercise of that or any other right or remedy.
14. Jurisdiction
14.1 These Conditions shall be governed by and construed in accordance with the laws of England and Wales, save that:
(a) if the Auction is held in Scotland, in accordance with the laws of Scotland; or
(b) if the Auction is held in Northern Ireland, in accordance with the laws in Northern Ireland (where applicable).
15. Guidance on Registration
15.1 The Auctioneer reserves the right to decline a bidder’s registration to bid without notice or recourse.
15.2 The Auctioneer reserves the right to request a deposit from all or any bidders at any time.
15.3 Unless an Invoice is amended within 1 business day as per point 6.4, to state that the name should be changed to a Company. Then the registered bidder is always liable for any outstanding invoice.
15.4 If the invoice is changed to a company as per point 6.4 and the company goes into liquidation or is dissolved then the original registered bidder will still be liable for any outstanding debt.
15.5 We reserve the right to request to Companies House that any company that has an outstanding debt is halted from dissolution until the debt is cleared.
15.6 A bidder must give their full name at registration, initials and nicknames are not valid.
15.7 If you are purchasing an item through third party finance, this needs to be pre-arranged so that there is no delay in payment.
16. General Conditions
16.1 All our telephone calls are recorded. We reserve the right to use them as evidence in the event of a dispute.
16.2 All auctions are Business to Business transactions and not a retail transaction.
16.3 The contract of sale is between the Vendor and the purchaser, William George, its staff and subsidiaries are the brokers to ease the transaction and is not liable whatsoever.
16.4 Online Auctions are not governed by Consumer Protection (Distance Selling) Regulations 2000 or the Cancellation of Contracts made in a Consumer’s home or place of work Regulations 2008. A buyer can only enact their right to cancel a sale in the event the goods are deemed to be materially different to the description offered. The most current legislation is the Consumer Contracts Regulations 2013 which supersede any previous legislation.
17. Chargeable Rates
17.1 The following rates are charged in all cases
Director Rate £2200 per day or £350 per hour
Manager Rate £1500 per day or £280 per hour
Auctioneer Rate £600 per day or £75 per hour
Marketing Manager Rate £900 per day or £150 per hour
Accounts and Support Staff Rate £400 per day or £50 per hour
18. Dispute Resolution, Remedies and Set Off
18.1 In the event that a dispute arises between the Seller and a Buyer, the Seller will deal directly with the Buyer to find a negotiated settlement. If the Seller and the Buyer are unable to agree a negotiated settlement between themselves then (at the written request of either the Seller or the Buyer) the Auctioneer may, at its discretion, endeavour to negotiate a settlement between both parties. If the item has been described incorrectly or in a manner to mislead, then the Auctioneer will look more favourably on the Buyer. If a resolution cannot be reached within a reasonable time frame, then the Auctioneer will make a decision that will be binding.
In any case, the buyer will have 10 days from receipt of their item in which to raise a dispute regarding the good received. The buyer should notify the vendor and auctioneer at the earliest opportunity, but no more than 10 days after receipt, regarding any perceived issues. Complaints or issues raised after this time frame should be directed to the vendor and the auctioneer cannot accept any liability for issues raised outside of this time frame.
18.2 The buyer is advised to check any and all goods immediately on receipt or at the point of collection and raise any issues at the earliest possible point. By signing for delivery of goods the buyer is accepting that the goods have been received as per the description, and so should ensure they are checked appropriately, or explicitly sign to say, ‘goods received unchecked’. Goods identified as not matching their description should not be removed from site by the buyer if collecting and the issues raised with the vendor on collection or by telephone or email to the auctioneer immediately if a resolution cannot be found.
18.3 In the event that a refund is due from the Seller to a Buyer in relation to any Goods, the Auctioneer will endeavour to make the refund from the proceeds of the Seller’s sales held on his Auction Account. If the said Auction Account contains no or insufficient funds, the Seller must make payment of the full amount or the balance (as the case may be) within 24 hours of the request of such payment by the Auctioneer. [The Auctioneer will look to reclaim a minimum of 50% of the lost commission for the refund of an item from the Seller. Payment must be made within 24 hours of the request of payment to the Seller.]
18.4 The Auctioneer may deduct the Buyer’s Premium and any other remuneration and/or charges payable to it by the Seller and/or the Buyer from any sum received by the Auctioneer from the Buyer of any Goods prior to accounting to the Seller for the balance.
18.5 In the event that the Auctioneer holds any funds in the Seller’s Auction Account to the credit of the Seller at any time, the Seller agrees, and the Auctioneer is authorised to set off against such credit balance any undisputed amount owed to it by the Seller under these Conditions in relation to any Lot or Lots, or under the Auctioneer’s terms and conditions for Buyers in circumstances where the Seller owes money to the Auctioneer as buyer of any other Goods.
19. Disputes in relation to Diamonds, Gemstones and Jewellery
19.1 In relation to disputes involving Diamonds, Gemstones and Jewellery, there is a standard procedure which will be employed in order to reach a resolution.
Items of this nature called into question will be sent to the Independent AnchorCert Gem Lab at the Assay Office in Birmingham to be tested for the characteristics called into question.
On receipt of the report from AnchorCert their findings will be treated as final.
If the item tested is found to be as described in auction, the item will be returned to the buyer who shall be liable for the costs associated with the assessment.
In the event the item is materially different to the description provided in auction then the seller will be liable to refund the buyer for the full amount paid, the auctioneer for 100% of the buyer’s premium, and the costs associated with the assessment.
The item will be returned to the seller on receipt of these funds in full. Responsibility for ensuring that the description is accurate lies entirely with the seller prior to listing.
In all cases the AnchorCert report shall provide the basis for the mediation and the Auctioneers decision is final taking into consideration some tolerance for minor discrepancies. The overarching principle in determining any dispute is that all parties are treated fairly and with respect in the circumstances.
Auction End Date: Wednesday 22nd March 2023 from 2pm
Payment Due Date: Friday 24th March 2023 by 4pm
Delivery Information: This is a multi-site auction, please refer to each lot for delivery information.
Sale Currency: GBP
Buyer's Premium: 25%
VAT on Hammer: Please refer to each lot
VAT on Buyers Premium: 20%
Before You Bid
* All Lots are subject to a buyer’s premium (BP), this is shown in the auction catalogue page and also on each lot page
* VAT is always applicable to the BP; each lot will state if VAT is applicable to the hammer price
* Payment from outside the UK will be subject to a £10 charge
* We accept card payment for amounts under £1000
* We do not accept card payments over £1000, or cash on collection, values over £1000 is to be made by bank transfer
* If you are exporting goods won in the auction. The VAT on Hammer must be paid first, and will only be refunded on receipt of proof of export
* Please note that late payment and collection fees will be added where applicable
* This is not a retail sale please make yourself aware of the terms and conditions
Close